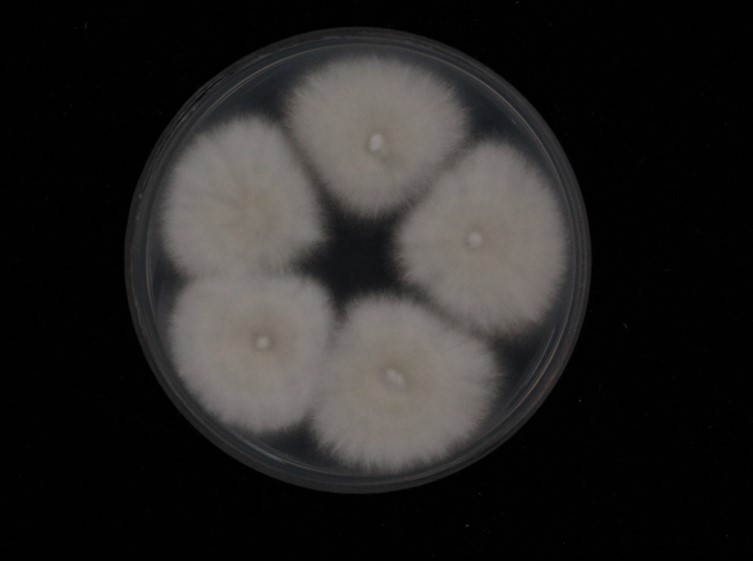

Holotype:
THAILAND, Chiang Mai Province, Kanlayaniwatthana District, 23 Nov. 2015, K. Tasanathai, S. Mongkolsamrit, D. Thanakitpipattana, W. Noisripoom, R. Promharn, P. Srikitikulchai, S. Wongkanoun, holotype BBH 40750, ex-type living culture TBRC 7256.
Habitat:
Leaf litter, underside of leaf.
Host:
Coleoptera larva, lepidopteran pupa.
Description:
Multiple  stromata arising from the abdominal regions of the insect host (body size 8 × 2 mm). Stromata white to pale yellow, cylindrical to clavate, 8-10 × 1-1.5 mm, upper part fertile, white to pale yellow, 4-6 × 1.5-2 mm.
stromata arising from the abdominal regions of the insect host (body size 8 × 2 mm). Stromata white to pale yellow, cylindrical to clavate, 8-10 × 1-1.5 mm, upper part fertile, white to pale yellow, 4-6 × 1.5-2 mm.  Perithecia superficial, densely packed, obpyriform, 300-350 × 150-200 μm.
Perithecia superficial, densely packed, obpyriform, 300-350 × 150-200 μm.  Asci cylindrical, 8-spored, up to 300 μm long, 2.5-3 μm wide. Ascospores hyaline, whole, bola-shaped, 3- or 4-septate, 250-290 × 1 μm, central part filiform, terminal part narrowly fusiform, 50-88 × 1.5 μm. Occasionally, isaria-like morph produced midway along the stroma below the perithecial layer.
Asci cylindrical, 8-spored, up to 300 μm long, 2.5-3 μm wide. Ascospores hyaline, whole, bola-shaped, 3- or 4-septate, 250-290 × 1 μm, central part filiform, terminal part narrowly fusiform, 50-88 × 1.5 μm. Occasionally, isaria-like morph produced midway along the stroma below the perithecial layer.  Phialides 5-10 × 2-3 μm, with a swollen, ellipsoidal basal portion, tapering into a long neck, 1.5-3 × 1 μm.
Phialides 5-10 × 2-3 μm, with a swollen, ellipsoidal basal portion, tapering into a long neck, 1.5-3 × 1 μm.  Conidia in chains, hyaline, ellipsoidal to cylindrical, 4-8 × 1.5-2 μm. Asexual morph: Numerous synnemata growing all over the host (specimen size 8-10 × 5 mm). Synnemata up to 1.5 mm long and ca 0.5 mm broad, powdery because of heavy sporulation, pale cream. Conidiophores usually biverticillate with phialides in whorls of three. Phialides 4-8 × 2-4 μm, with a globose basal portion, tapering into a distinct neck, 1-3 × 1 μm. Conidia in chains, hyaline, cylindrical to ellipsoidal, 1-celled, 3-5 × 2-3 μm.
Conidia in chains, hyaline, ellipsoidal to cylindrical, 4-8 × 1.5-2 μm. Asexual morph: Numerous synnemata growing all over the host (specimen size 8-10 × 5 mm). Synnemata up to 1.5 mm long and ca 0.5 mm broad, powdery because of heavy sporulation, pale cream. Conidiophores usually biverticillate with phialides in whorls of three. Phialides 4-8 × 2-4 μm, with a globose basal portion, tapering into a distinct neck, 1-3 × 1 μm. Conidia in chains, hyaline, cylindrical to ellipsoidal, 1-celled, 3-5 × 2-3 μm.
Culture characteristics:
Colonies on PDA moderately fast-growing, ca 4 cm diam in 14 d at 25 °C, white, cottony with high mycelial density, reverse pale yellow. Prostrate hyphae smooth, septate, hyaline, 2–3 μm diam. Conidial structures consisting of erect conidiophores either arising from the aerial hyphae and prostrate hyphae, verticillate with phialides in whorls of two to five or occasionally singly along the aerial hyphae. Phialides 6–9 × 2–4 μm, with a globose basal portion, tapering into a long neck, 2–3×1μm. Conidia in chains, hyaline, cylindrical to ellipsoidal or reniform, 1-celled, 3–8 × 2–3.5 μm. Chlamydospores not observed. Synnemata observed in some strains after 45 d, white, ca 5 mm long, 2–3 mm wide.
Colonies on PDA moderately fast-growing, ca 4 cm diam in 14 d at 25 °C, white, cottony with high mycelial density, reverse pale yellow. Prostrate hyphae smooth, septate, hyaline, 2–3 μm diam. Conidial structures consisting of erect conidiophores either arising from the aerial hyphae and prostrate hyphae, verticillate with phialides in whorls of two to five or occasionally singly along the aerial hyphae. Phialides 6–9 × 2–4 μm, with a globose basal portion, tapering into a long neck, 2–3×1μm. Conidia in chains, hyaline, cylindrical to ellipsoidal or reniform, 1-celled, 3–8 × 2–3.5 μm. Chlamydospores not observed. Synnemata observed in some strains after 45 d, white, ca 5 mm long, 2–3 mm wide.
Reference:
Mongkolsamrit S, Noisripooma W, Thanakitpipattana D, et al. (2018). Disentangling cryptic species with isaria-like morphs in Cordycipitaceae. Mycologia 110: 230–257.
DOI: https://doi.org/10.1080/00275514.2018.1446651Species |
Strain |
Compound |
Pubchem CID |
Biological activity |
Reference |
|---|
|
Strain |
ITS | LSU | RPB1 | RPB2 | TEF1 |
|---|---|---|---|---|---|
| TBRC 7253 | MF140739 | MF140705 | MF140774 | MF140798 | MF140825 |
| TBRC 7254 | MF140738 | MF140704 | MF140773 | MF140797 | MF140824 |
| TBRC 7255 | MF140737 | MF140703 | MF140772 | MF140796 | MF140823 |
| TBRC 7256 | MF140736 | MF140702 | MF140771 | MF140795 | MF140822 |
| TBRC 7257 | MF140735 | MF140701 | MF140770 | MF140794 | MF140821 |